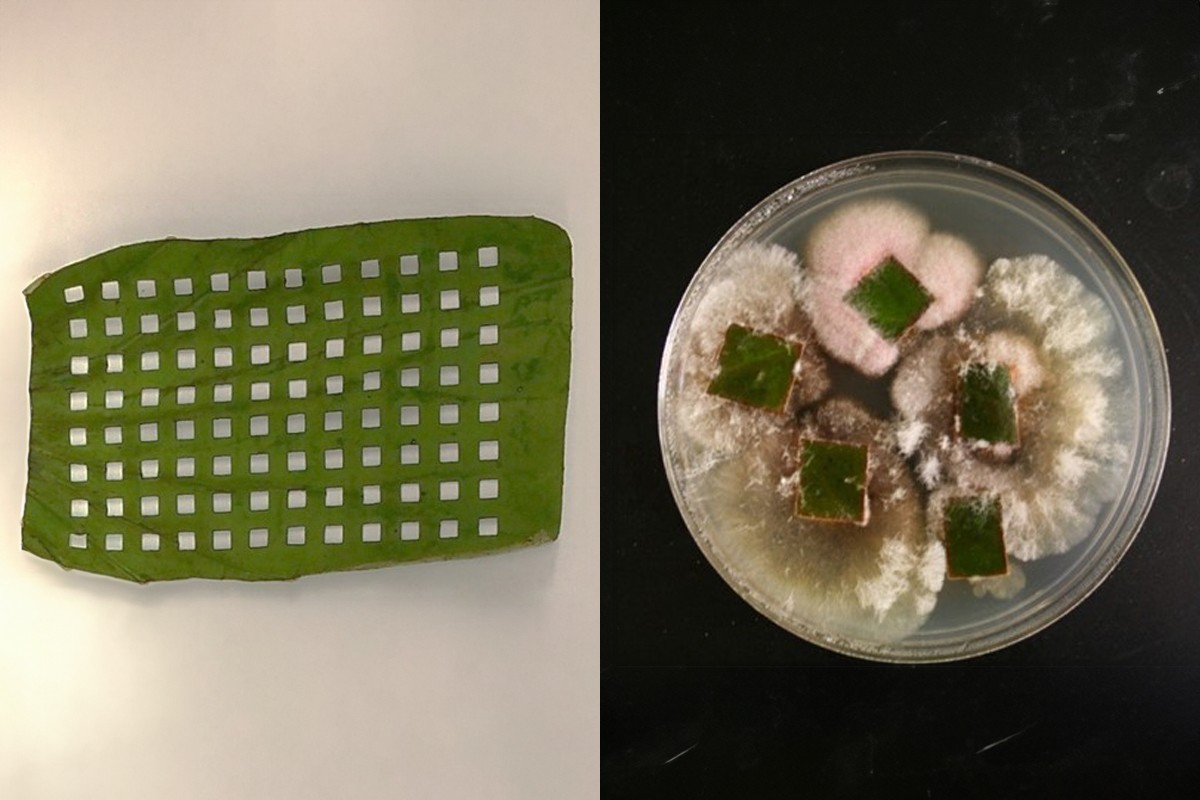

睡莲可能因主演法国印象派艺术家克劳德-莫奈的作品而闻名于世,但睡莲也可能拥有一种分子秘密武器,可以帮助我们与真菌感染作斗争。继病毒和细菌之后,真菌是最致命的病原体,而且和细菌一样,它也在迅速适应,对目前的医疗干预措施产生抗药性。
官方数据显示,每年约有 8000 名美国人死于真菌感染,但这一数字可能要高得多,因为许多病例未被诊断出来,而且作为一种"机会性病原体",真菌可以攻击衰弱的免疫系统,导致复杂的并发症。

世界卫生组织去年呼吁对真菌病原体给予紧急关注,因为在气候变化的刺激下,真菌病原体正变得越来越普遍,威胁也越来越大。
不过,也有一些好消息。俄克拉荷马大学(UO)的科学家们可能在一种睡莲或荷花中发现了一种分子,可以抵御真菌感染。
俄克拉荷马大学道奇家族文理学院化学与生物化学系教授罗伯特-西切维奇(Robert Cichewicz)说:"让我们感到兴奋的分子叫做persephacin。这一抗真菌发现似乎能对广谱的传染性真菌起作用,而且它对人体细胞无毒,这一点非常重要,因为目前的许多治疗方法都对人体有毒。"

研究真菌长达二十年的 Cichewicz 指出,植物为抵御攻击而开发的策略可能是我们抵御病原体威胁的最佳选择。
与细菌一样,病原真菌也能快速适应和规避现有的治疗方法;在生物进化的'军备竞赛'中,这是一项令人印象深刻的壮举,科学界不得不奋起直追。
Cichewicz说:"真菌遍布植物界,植物和真菌经常一起工作。"其中一些真菌会杀死竞争对手,或阻止昆虫啃食植物。我们假设,如果这些居住在植物中的真菌(被称为内生菌)能够通过杀死入侵的真菌来帮助植物抵御感染,那么这些分子或许也能保护人类和动物免受真菌病原体的侵害。事实证明,我们是对的。"
虽然它可能不是一颗银弹,但persephacin 抵御真菌感染的能力是科学家们在这一令人沮丧的领域取得的一项有希望的进展。
Cichewicz说:"抗真菌抗药性不断演变,这可能会提供一种新的选择。这就是为什么这种分子如此令人兴奋。"
这项研究发表在《天然产品杂志》上。